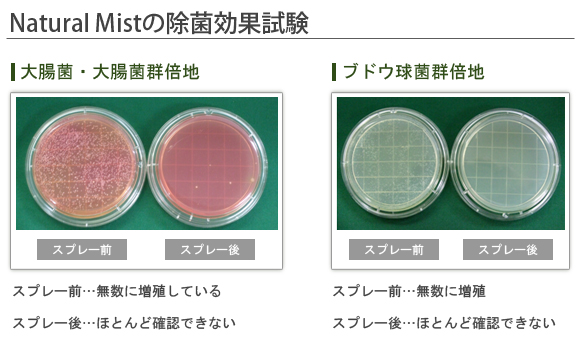

除菌・消臭効果のある・ハーブ・フルーツエキス・植物エキス・イカキトサンから生まれました。安心・安全に生活空間をリフレッシュ!!
化学物質や合成香料・アルコールを含まず、さわやかなハーブの香りが広がります。

ナチュラルミストは、ユーカリ葉エキス、グレープフルーツ種子、松ノ木エキス、イカキトサン、ラベンダー、ペパーミントを成分とした、天然成分の除菌+消臭スプレーです。

マスクの表面にかけてウイルス対策!
消臭と除菌にペットがなめても安全。
万が一のペットの粗相にも、すぐに除菌消臭。
いつも快適に。
直接接触部分の除菌に・・
前日とお出かけ前にスプレーして、足元安心!
布製品に付着した
気になる臭いも快適に除菌消臭!
お子様から大人まで安心
水洗いや洗浄しにくい衣類に染み付く
イヤ~な臭いも消臭
車内のこもった臭いやハンドル・シートの除菌。
| 試験菌 | 対象 | 生菌数(/ml) | |
|---|---|---|---|
| 開始時(※) | 60分後 | ||
| 大腸菌 | 検体 | 1.2×106 | <10 |
| 対照 | 1.2×106 | 1.4×106 | |
| 黄色ブドウ球菌 | 検体 | 1.2×106 | <100 |
| 対照 | 1.2×106 | 1.2×106 | |
※菌液接種直後の対照の生菌数を測定し、開始時とした。
